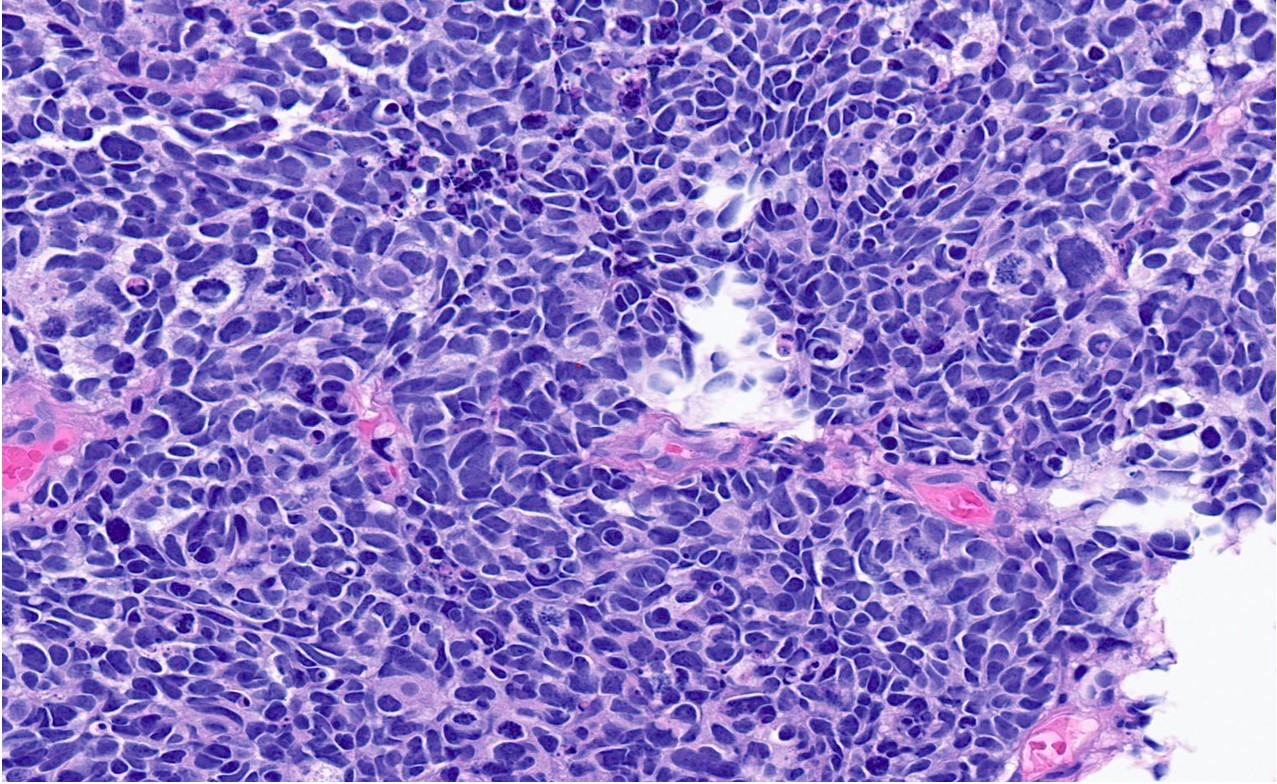
Mesanenin Küçük Hücreli Nöroendokrin Karsinomu

Mesanenin Küçük Hücreli Nöroendokrin Karsinomu
Mesanenin Küçük Hücreli Nöroendokrin Karsinomu, mesanenin nadir görülen, ancak son derece agresif bir seyir gösteren bir mesane kanseri türüdür. Küçük hücreli nöroendokrin kanserler, genellikle akciğerlerde görülmekle birlikte, mesane gibi başka organlarda da gelişebilir. Bu tür kanserler, vücudun nöroendokrin hücrelerinden kaynaklanır. Bu hücreler hormonları ve kimyasal sinyalleri düzenleyen hücrelerdir.
Mesanenin Küçük Hücreli Nöroendokrin Karsinomu
Nadir görülürler: Küçük hücreli nöroendokrin karsinom, mesane kanserlerinin yalnızca %1-2’sini oluşturur.
Agresif seyir gösterirler: Küçük hücreli nöroendokrin karsinom, genellikle hızlı büyüyen ve vücutta hızla yayılma eğiliminde olan bir kanser türüdür. Bu nedenle tedavisi zordur ve genellikle erken evrede tespit edilmesi zordur.
Hormon salgılama: Bu tümörler, nöroendokrin hücrelerin özelliği olarak, vücutta farklı hormonların üretimine yol açabilir.
Mesanenin Küçük Hücreli Nöroendokrin Karsinom Belirtileri
Mesanenin küçük hücreli nöroendokrin karsinomu, genellikle aşağıdaki belirtilerle kendini gösterir:
- Hematuri (kanlı idrar): Mesane kanserinin en yaygın belirtisidir. Kanlı idrar, genellikle erken dönemde ortaya çıkar.
- İdrar yaparken ağrı veya yanma: Kanserin mesaneye baskı yapması sonucu idrar yaparken ağrı olabilir.
- Sık idrara çıkma: Mesaneye baskı yaparak sık idrara çıkma ihtiyacı doğabilir.
- Pelvik ve karın altı ağrıları: Kanser ilerledikçe, çevre dokulara baskı yaparak ağrıya yol açabilir.
- Genel yorgunluk ve kilo kaybı: Agresif kanserlerin yayılmaya başlamasıyla birlikte genel zayıflama, halsizlik gibi belirtiler görülebilir.
Mesanenin Küçük Hücreli Nöroendokrin Karsinomunun Tanısı
Tanı süreci genellikle birkaç aşamadan oluşur. Bunlar;
Görüntüleme Testleri
- Ultrason: Mesanedeki kitlenin büyüklüğü ve yerleşimi hakkında bilgi verir.
- BT (Bilgisayarlı Tomografi) ve MRG (Manyetik Rezonans Görüntüleme): Kanserin yayılmasını görmek için kullanılır. Ayrıca pelvik bölgedeki yerleşimi değerlendirmek için de faydalıdır.
Sistoskopi: Mesanenin içini doğrudan görmek için kullanılan bir yöntemdir. Sistoskopla mesane içine girilir ve tümörlerden bir biyopsi alınarak patolojik inceleme yapılır.
Patolojik İnceleme: Biopsi örneği mikroskop altında incelenir. Küçük hücreli nöroendokrin karsinomu, özellikle hücresel morfolojisi, hızlı bölünme ve sıkı hücre kümeleri ile belirgin olur.
Mesanenin Küçük Hücreli Nöroendokrin Karsinomunun Tedavisi
Mesanenin küçük hücreli nöroendokrin karsinomu nadir ve agresif bir kanser türüdür. Tedavisi genellikle birden fazla yöntemi içerir ve kanserin evresine, hastanın genel sağlık durumuna ve kişisel tercihlerine göre değişir. Genellikle ilk basamak tedavi, tümörün cerrahi olarak çıkarılmasıdır (sistektomi). Bu, mesanenin tamamının veya bir kısmının alınmasını içerebilir. Ameliyat öncesi veya sonrası kemoterapi, radyoterapi veya immünoterapi gibi ek tedaviler de kullanılabilir. Kemoterapi, kanser hücrelerini öldürmek için ilaçların kullanılmasını içerirken, radyoterapi yüksek enerjili ışınlar kullanarak kanser hücrelerini hedef alır. İmmünoterapi ise vücudun bağışıklık sistemini kanserle savaşmak için güçlendirir. KHNK’nin hızlı büyüme ve yayılma eğilimi nedeniyle, erken teşhis ve tedavi hayati önem taşır. Ne yazık ki, bu kanser türü genellikle ileri evrelerde teşhis edilir ve bu da tedaviyi zorlaştırır.
Mesane küçük hücreli nöroendokrin karsinomu, genellikle agresif seyrettiği için tedavi süreci çok önemlidir. Tedavi yöntemleri şunları içerebilir:
Kemoterapi: Küçük hücreli kanserler genellikle kemoterapiye duyarlıdır. Cisplatin ve etoposid gibi ilaçlar, bu tür tümörlerin tedavisinde sıklıkla kullanılır. Kemoterapi, kanserin sistemik olarak vücuda yayılmasını önlemeye çalışır.
Radyoterapi: Kanserin lokalize olduğu durumlarda, tümörün küçültülmesi için radyoterapi kullanılabilir. Ancak küçük hücreli kanserler genellikle hızlı yayıldığı için, radyoterapi yalnızca yardımcı bir tedavi olabilir.
Cerrahi Müdahale: Cerrahi tedavi, tümör yalnızca mesanede sınırlıysa ve erken evrede teşhis edilmişse uygulanabilir. Ancak çoğu vakada kanserin ilerlemiş evrede olduğu görülür ve cerrahi tedavi daha az etkili olabilir.
İmmünoterapiler: Son yıllarda immünoterapilerin bazı kanser türlerinde etkinliği gösterilmiştir. Ancak bu tedavi mesane küçük hücreli nöroendokrin karsinomu için henüz rutin bir tedavi olarak kabul edilmemektedir.
Prognoz
Mesane küçük hücreli nöroendokrin karsinomu, genellikle kötü prognoza sahip bir hastalıktır çünkü bu tümörler hızla büyür ve yayılır. Erken tanı ve agresif tedavi, bazı hastalar için olumlu sonuçlar doğurabilir. Ancak çoğu vakada, hastalık tanı konduğunda ileri evrede olduğu için tedaviye yanıt sınırlı olabilir. Bu kanser türü, çoğu zaman metastaz yaparak organlara yayılabilir.